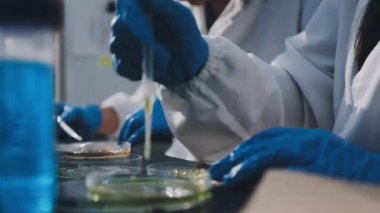
Arka plan için mikroskop ile Bilim tıbbi laboratuvar ekipmanları

İhlal Bildirim Formu
En Çok Aranan Kelimeler
donanıminsanlarSıvıSağlıkİlaç.TıbbiteknolojiDoktorTest etörnekbiyolojiKimyasalKimyagerDeneyLaboratuvarBilimKeşifanalizvirüskimyaaraştırmaBilimselTeknisyenbiyokimyaBiyoteknoloji.bilim adamıMikroskopMikrobiyolojiBenzer İçerikler


Özel Boyut
(1920 x 1080, mov)
Geniş Lisanslama
(1920 x 1080, mov)
Eser Sahibi:
Tarih:
Warning: substr_count(): Empty substring in /home/lisansio/public_html/wp-content/themes/telifport_v3/inc-frontend/modal-urun-bilgileri.php on line 288